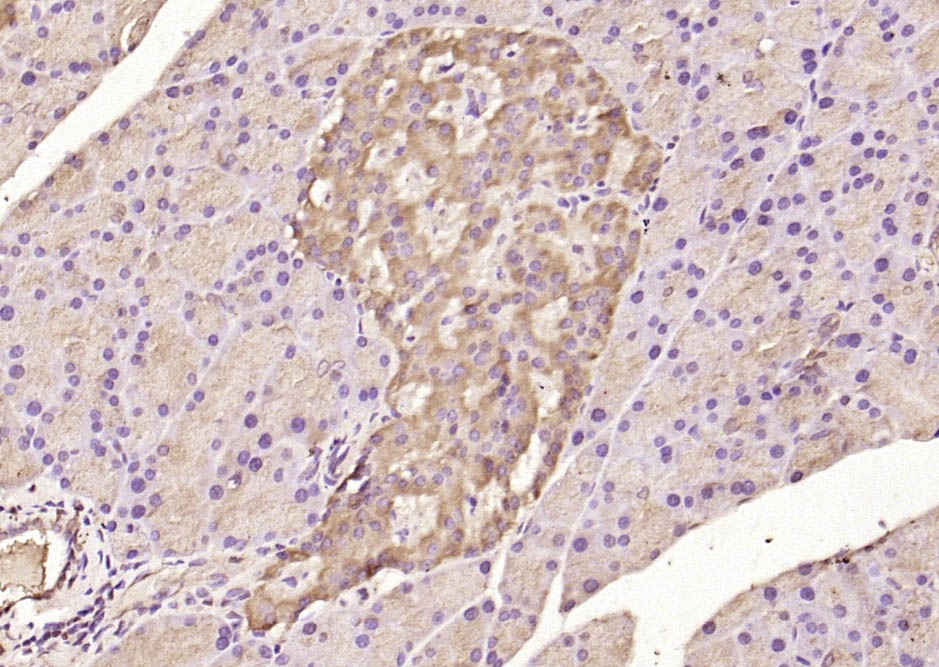
产品细节图片14

相关产品推荐更多 >
万千商家帮你免费找货
0 人在求购买到急需产品
- 详细信息
- 文献和实验
- 技术资料
- 应用范围:
产品信息以Bioss网站为准
- 规格:
50ul/100ul/200ul
| 规格: | 50ul | 产品价格: | ¥1180.0 |
|---|---|---|---|
| 规格: | 100ul | 产品价格: | ¥1980.0 |
| 规格: | 200ul | 产品价格: | ¥2800.0 |
| 产品编号 | bs-1634R |
| 英文名称 | ATF6 Rabbit pAb |
| 中文名称 | 活化转录因子6抗体 |
| 英文别名 | Activating transcription factor 6 alpha; Activating transcription factor 6; ATF 6; ATF6 alpha; ATF6; ATF6-alpha; ATF6A; ATF6A_HUMAN; cAMP dependent transcription factor ATF 6 alpha; cAMP-dependent transcription factor ATF-6 alpha; Cyclic AMP dependent transcription factor ATF 6 alpha; DKFZp686P2194; ESTM49; FLJ21663; Processed cyclic AMP dependent transcription factor ATF 6 alpha; Processed cyclic AMP-dependent transcription factor ATF-6 alpha. |
| 产品应用 | WB=1:500-2000, IHC-P=1:100-500, IHC-F=1:100-500, ICC/IF=1:100-500, IF=1:100-500, Flow-Cyt=1μg /test Not yet tested in other applications. |
| 交叉反应 | Human, Mouse, Rat (Pig, Cow, Horse, Rabbit) |
| 抗体来源 | Rabbit |
| 免疫原 | KLH conjugated synthetic peptide derived from human ATF6 |
| 亚型 | IgG |
| 性状 | Liquid |
| 纯化方法 | affinity purified by Protein A |
| 克隆类型 | Polyclonal |
| 理论分子量 | 75 kDa |
| 浓度 | 1mg/ml |
| 储存液 | 0.01M TBS (pH7.4) with 1% BSA, 0.02% Proclin300 and 50% Glycerol. |
| 研究领域 | Epigenetics and Nuclear Signaling > ChIP assays > ChIP antibodies Epigenetics and Nuclear Signaling > Transcription > Domain Families > HLH / Leucine Zipper > Leucine Zipper |
| 亚基 | Homodimer and heterodimer with ATF6-beta. The dimer interacts with the nuclear transcription factor Y (NF-Y) trimer through direct binding to NF-Y subunit C (NF-YC). Interacts also with the transcription factors GTF2I, YY1 and SRF. |
| 亚细胞定位 | Endoplasmic reticulum membrane; Single-pass type II membrane protein. Processed cyclic AMP-dependent transcription factor ATF-6 alpha: Nucleus. Note=Under ER stress the cleaved N-terminal cytoplasmic domain translocates into the nucleus. |
| 组织特异性 | Ubiquitous. |
| 翻译后修饰 | During unfolded protein response an approximative 50 kDa fragment containing the cytoplasmic transcription factor domain is released by proteolysis. The cleavage seems to be performed sequentially by site-1 and site-2 proteases. N-glycosylated. The glycosylation status may serve as a sensor for ER homeostasis, resulting in ATF6 activation to trigger the unfolded protein response (UPR). Phosphorylated in vitro by MAPK14/P38MAPK. |
| 相似性 | Belongs to the bZIP family. ATF subfamily. Contains 1 bZIP (basic-leucine zipper) domain. |
| 功能 | Transcription factor that acts during endoplasmic reticulum stress by activating unfolded protein response target genes. Binds DNA on the 5'-CCAC[GA]-3'half of the ER stress response element (ERSE) (5'-CCAAT-N(9)-CCAC[GA]-3') and of ERSE II (5'-ATTGG-N-CCACG-3'). Binding to ERSE requires binding of NF-Y to ERSE. Could also be involved in activation of transcription by the serum response factor. |
| 保存条件 | Shipped at 4℃. Store at -20℃ for one year. Avoid repeated freeze/thaw cycles. |
| 注意事项 | This product as supplied is intended for research use only, not for use in human, therapeutic or diagnostic applications. |
| 背景资料 | ATF6 is a transcription factor that acts during endoplasmic reticulum stress by activating unfolded protein response target genes. It binds DNA on the 5'-CCAC[GA]-3'half of the ER stress response element (ERSE) (5'-CCAAT-N(9)-CCAC[GA]-3') and of ERSE II (5'-ATTGG-N-CCACG-3'). Binding to ERSE requires binding of NF-Y to ERSE. ATF6 could also be involved in activation of transcription by the serum response factor. ATF6 exists as a homodimer and heterodimer with ATF6 beta. The dimer interacts with the nuclear transcription factor Y (NF-Y) trimer through direct binding to NF-Y subunit C (NF-YC). It also interacts with the transcription factors GTF2I, YY1 and SRF. Under ER stress the cleaved N-terminal cytoplasmic domain translocates into the nucleus. The basic domain of ATF6 functions as a nuclear localization signal and the basic leucine zipper domain is sufficient for association with the NF-Y trimer and binding to ERSE. During the unfolded protein response an approximately 50 kDa fragment containing the cytoplasmic transcription factor domain is released by proteolysis. The cleavage seems to be performed sequentially by site 1 and site 2 proteases. ATF6 is N glycosylated, phosphorylated in vitro by MAPK14/P38MAPK and belongs to the bZIP family. |
| 应用 | 推荐稀释比例 |
| {WB} | {1:500-2000} |
| {IHC-P} | {1:100-500} |
| {IHC-F} | {1:100-500} |
| {ICC/IF} | {1:100-500} |
| {IF} | {1:100-500} |
| {Flow-Cyt} | {1μg /test} |

Antigen retrieval: citrate buffer ( 0.01M, pH 6.0 ), Boiling bathing for 15min; Block endogenous peroxidase by 3% Hydrogen peroxide for 30min; Blocking buffer (normal goat serum,C-0005) at 37℃ for 20 min;
Incubation: Anti-ATF6 Polyclonal Antibody, Unconjugated(bs-1634R) 1:200, overnight at 4°C, followed by conjugation to the secondary antibody(SP-0023) and DAB(C-0010) staining

Primary Antibody:Rabbit Anti-ATF6 antibody(bs-1634R), Dilution: 1μg in 100 μL 1X PBS containing 0.5% BSA;
Isotype Control Antibody: Rabbit IgG(orange) ,used under the same conditions );
Secondary Antibody: Goat anti-rabbit IgG-PE(white blue), Dilution: 1:200 in 1 X PBS containing 0.5% BSA.
Protocol
The cells were fixed with 2% Paraformaldehyde (10 min). Primary antibody (bs-1634R, 1μg /1x10^6 cells) were incubated for 30 min on the ice, followed by 1 X PBS containing 0.5% BSA + 1 0% goat serum (15 min) to block non-specific protein-protein interactions. Then the Goat Anti-rabbit IgG/PE antibody was added into the blocking buffer mentioned above to react with the primary antibody at 1/200 dilution for 30 min on ice. Acquisition of 20,000 events was performed.



Primary Antibody (green line): Rabbit Anti-ATF6 antibody (bs-1634R)
Dilution: 1μg /10^6 cells;
Isotype Control Antibody (orange line): Rabbit IgG .
Secondary Antibody : Goat anti-rabbit IgG-FITC
Dilution: 1μg /test.
Protocol
The cells were fixed with 4% PFA (10min at room temperature)and then permeabilized with 90% ice-cold methanol for 20 min at-20℃.The cells were then incubated in 5%BSA to block non-specific protein-protein interactions for 30 min at room temperature .Cells stained with Primary Antibody for 30 min at room temperature. The secondary antibody used for 40 min at room temperature. Acquisition of 20,000 events was performed.

Primary Antibody (green line): Rabbit Anti-ATF6 antibody (bs-1634R)
Dilution: 1μg /10^6 cells;
Isotype Control Antibody (orange line): Rabbit IgG .
Secondary Antibody : Goat anti-rabbit IgG-PE
Dilution: 1μg /test.
Protocol
The cells were fixed with 4% PFA (10min at room temperature)and then permeabilized with 90% ice-cold methanol for 20 min at-20℃.The cells were then incubated in 5%BSA to block non-specific protein-protein interactions for 30 min at room temperature .Cells stained with Primary Antibody for 30 min at room temperature. The secondary antibody used for 40 min at room temperature. Acquisition of 20,000 events was performed.

Primary Antibody (green line): Rabbit Anti-ATF6 antibody (bs-1634R)
Dilution: 1μg /10^6 cells;
Isotype Control Antibody (orange line): Rabbit IgG .
Secondary Antibody : Goat anti-rabbit IgG-FITC
Dilution: 1μg /test.
Protocol
The cells were fixed with 4% PFA (10min at room temperature)and then permeabilized with 90% ice-cold methanol for 20 min at-20℃.The cells were then incubated in 5%BSA to block non-specific protein-protein interactions for 30 min at room temperature .Cells stained with Primary Antibody for 30 min at room temperature. The secondary antibody used for 40 min at room temperature. Acquisition of 20,000 events was performed.

Primary Antibody (green line): Rabbit Anti-ATF6 antibody (bs-1634R)
Dilution: 1μg /10^6 cells;
Isotype Control Antibody (orange line): Rabbit IgG .
Secondary Antibody : Goat anti-rabbit IgG-FITC
Dilution: 1μg /test.
Protocol
The cells were fixed with 4% PFA (10min at room temperature)and then permeabilized with 90% ice-cold methanol for 20 min at-20℃.The cells were then incubated in 5%BSA to block non-specific protein-protein interactions for 30 min at room temperature .Cells stained with Primary Antibody for 30 min at room temperature. The secondary antibody used for 40 min at room temperature. Acquisition of 20,000 events was performed.

风险提示:丁香通仅作为第三方平台,为商家信息发布提供平台空间。用户咨询产品时请注意保护个人信息及财产安全,合理判断,谨慎选购商品,商家和用户对交易行为负责。对于医疗器械类产品,请先查证核实企业经营资质和医疗器械产品注册证情况。
文献和实验[IF={{ 7.376 }}] {Qiuchi Chen. et al. Suppression of cideb under endoplasmic reticulum stress exacerbated hepatic inflammation by inducing hepatic steatosis and oxidative stress. FREE RADICAL BIO MED. 2022 May;185:67} {WB} {Fish}
[IF={{ 6.684 }}] {Balun Li. et al. Melatonin Promotes the Therapeutic Effect of Mesenchymal Stem Cells on Type 2 Diabetes Mellitus by Regulating TGF-β Pathway. Front Cell Dev Biol. 2021; 9: 722365} {IHC} {Dog}
[IF={{ 6.208 }}] {Yurong Fu. et al. Zearalenone Promotes LPS-Induced Oxidative Stress, Endoplasmic Reticulum Stress, and Accelerates Bovine Mammary Epithelial Cell Apoptosis. INT J MOL SCI. 2022 Jan;23(18):10925} {WB} {Bovine}
[IF={{ 5.793 }}] {Chunyue Wang. et al. Neuroprotective effects of verbascoside against Alzheimer’s disease via the relief of endoplasmic reticulum stress in Aβ-exposed U251 cells and APP/PS1 mice. J Neuroinflamm. 2020 Dec;17(1):1-16} {WB} {Human}
[IF={{ 5.3 }}] {Wenjing Lu. et al. 1α,25(OH)2D3 improves 17β-estradiol secretion and potentially alleviates endoplasmic reticulum stress in muskrat granulosa cells. BIOCHEM PHARMACOL. 2024 Dec;:116696} {WB} {Muskrat}
= NAL), appears to form upon oxidative cyclization of the nonfluorescent 2:1 lysine-HNE Michael adduct-Schiff base cross-link (Scheme 1). Polyclonal antibody (PAb) to the NAL-HNE fluorophore was raised in rabbit and found to be highly specific
/96T 2000/3000 进口分装 F0021 骨成型蛋白-9(BMP-9) ELISA 48T/96T 2000/3000 进口分装 F0022 BMP-R1A ELISA 48T/96T 2000/3000 进口分装 F0023 BMP-R2 ELISA 48T/96T 2000/3000 进口分装 F0024 BTC ELISA 48T/96T 2000/3100 进口分装 F0030 CAE-Ab ELISA 96
/96T 2000/3000 进口分装 F0021 骨成型蛋白-9(BMP-9) ELISA 48T/96T 2000/3000 进口分装 F0022 BMP-R1A ELISA 48T/96T 2000/3000 进口分装 F0023 BMP-R2 ELISA 48T/96T 2000/3000 进口分装 F0024 BTC ELISA 48T/96T 2000/3100 进口分装 F0030 CAE-Ab ELISA 96
技术资料暂无技术资料 索取技术资料










